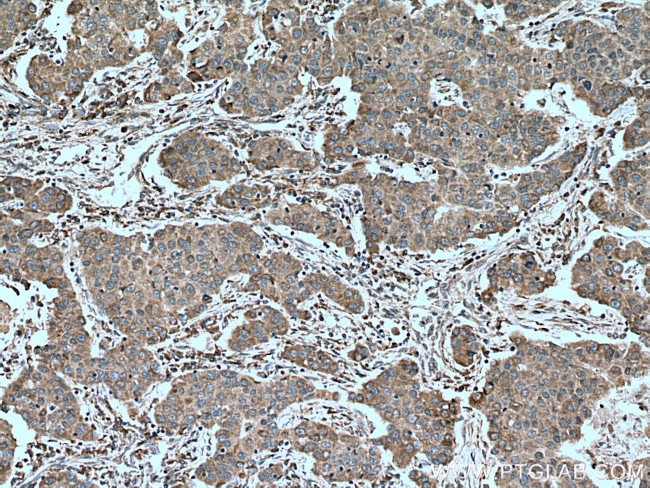
PALB2 Antibody in Immunohistochemistry (Paraffin) (IHC (P))

Search
Proteintech
PALB2 Polyclonal Antibody
{{$productOrderCtrl.translations['antibody.pdp.commerceCard.promotion.promotions']}}
{{$productOrderCtrl.translations['antibody.pdp.commerceCard.promotion.viewpromo']}}
{{$productOrderCtrl.translations['antibody.pdp.commerceCard.promotion.promocode']}}: {{promo.promoCode}} {{promo.promoTitle}} {{promo.promoDescription}}. {{$productOrderCtrl.translations['antibody.pdp.commerceCard.promotion.learnmore']}}
产品信息
14340-1-AP
种属反应
宿主/亚型
分类
类型
抗原
偶联物
形式
浓度
规格
纯化类型
保存液
内含物
保存条件
运输条件
产品详细信息
Immunogen sequence: TAELPASDS INPGNLQLVS ELKNPSGSCS VDVSAMFWER AGCKEPCIIT ACEDVVSLWK ALDAWQWEKL YTWHFAEVPV LQIVPVPDVY NLVCVALGNL EIREIRALFC SSDDESEKQV LLKSGNIKAV LGLTKRRLVS SSGTLSDQQV EVMTFAEDGG GKENQFLMPP EETILTFAEV QGMQEALLGT TIMNNIVIWN LKTGQLLKKM HIDDSYQASV CHKAYSEMGL LFIVLSHPCA KESESLRSPV FQLIVINPKT TLSVGVMLYC LPPGQAGRFL EGDVKDHCAA AILTSGTIAI WDLLLGQCTA LLPPVSDQHW SFVKWSGTDS HLLAGQKDGN IFVYHYS (841-1186 aa encoded by BC044254)
靶标信息
The breast cancer early onset proteins BRCA1 and BRCA2 are central to the repair of DNA damage by homologous recombination and are strongly associated with inherited breast and ovarian cancer. The protein PALB2 is required for the localization of BRCA2 to sites of DNA damage and like BRCA1 and 2 is a breast cancer susceptibility gene. PALB2 is thought to function through directly binding to BRCA1, which allows the PALB2 protein to organize BRCA2 and the recombinase RAD51 at the site of DNA damage. Analysis of the BRCA1-PALB2-BRCA2-RAD51network may allow predictions to be made of the responsiveness of a particular tumor to therapeutic treatments. At least four isoforms of PALB2 are known to exist.
仅用于科研。不用于诊断过程。未经明确授权不得转售。
生物信息学
蛋白别名: FLJ21816; mutant partner and localizer of BRCA2; Partner and localizer of BRCA2; unnamed protein product
基因别名: BC066140; BROVCA5; FANCN; PALB2; PNCA3; RGD1304759
UniProt ID: (Human) Q8ND31, (Mouse) Q3U0P1
Entrez Gene ID: (Human) 79728, (Rat) 293452, (Mouse) 233826